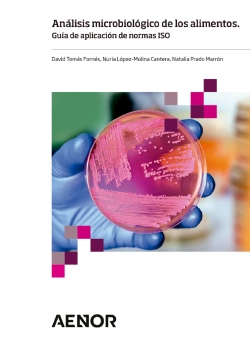
analisis microbiologico de los alimentos

"Análisis microbiológico de los alimentos. Guía de aplicación de normas ISO" es una nueva publicación de AENOR, que sintetiza y simplifica más de 25 normas ISO de uso habitual en el control de la seguridad y calidad de los alimentos, y facilita su implantación en la aplicación de métodos de ensayo microbiológicos en los laboratorio de análisis. Es un trabajo realizado por Natalia Prado Marrón, Nuria López-Molina Cantera y David Tomás Fornés.
Análisis microbiológico de los alimentos
Los peligros microbiológicos son una de las principales causas de enfermedades transmitidas por los alimentos, como por ejemplo la salmonelosis, la campilobacteriosis o la listeriosis. El análisis microbiológico de los alimentos permite detectar y realizar el recuento de gérmenes, con el objetivo de minimizar el riesgo y prevenir brotes de enfermedades de transmisión alimentaria.
Los métodos normalizados de análisis microbiológicos de los alimentos son una valiosa herramienta que permite a los laboratorios disponer de métodos de ensayo reconocidos internacionalmente, que aseguran que los resultados obtenidos son comparables y fiables. Juegan, pues, un papel muy relevante para garantizar la seguridad y calidad de los alimentos, asi como su comercio.
Guía de aplicación de normas ISO
El grupo de normas de aplicación en microbiología alimentaria es muy extenso y completo, y su correcta aplicación puede llegar a ser compleja.
La guía "Análisis microbiológico de los alimentos. Guía de aplicación de normas ISO", busca facilitar la comprensión y la implantación de más de veinticinco normas fundamentales, que incluyen las principales guías y métodos de análisis microbiológico de uso habitual en el control de la seguridad y calidad de los alimentos. Incluye resúmenes, gráficos y diagramas esquemáticos de las normas de referencia UNE e ISO más importantes.
La guía ha sido escrita por Natalia Prado Marrón, Nuria López-Molina Cantera, David Tomás Fornés, expertos miembros de la Sociedad Española de Microbiología (SEM) e Integrantes del Grupo Especializado de Microbiología de los Alimentos, y publicada por AENOR.
El trabajo está dirigido a un público diverso, especialmente profesionales y estudiantes del sector. Incluye conceptos e información relevante para las personas que se acercan por primera vez a las técnicas de análisis microbiológicos, así como referencias que permiten profundizar en los métodos y que sirven de guía, tanto en el ámbito académico como en el profesional. Por otra parte, en el caso de la aplicación de los métodos de ensayo microbiológicos en un laboratorio de análisis, el objetivo de la guía es facilitar la implantación de las normas.
El alcance del libro está limitado a las guías generales que deben ser de uso común para todos los laboratorios de microbiología, a los métodos de ensayo que tienen su fundamento en técnicas de cultivo y a aquellos microorganismos de mayor relevancia para la industria alimentaria, incluyendo los señalados en la legislación vigente, como Escherichia coli, Salmonella spp. o Listeria spp.
Así pues, no se incluyen aquellos métodos relacionados con el empleo de técnicas como la PCR ni algunas normas que, si bien están relacionadas con la microbiología alimentaria, no aplican técnicas convencionales (p. ej.: virus entéricos, parásitos, toxinas).
En 22 capítulos se abordan normas relacionadas con:
- Medios de cultivo
- Preparación de muestras
- Verificación de métodos de ensayo
- Colonias a 30 ºC
- Microorganismos psicrotrofos
- Bacterias ácido lácticas
- Mohos y levaduras
- Enterobacterias
- Coliformes
- Escherichia coli
- Salmonella spp.
- Yersinia enterocolitica patógena
- Listeria monocytogenes y Listeria spp
- Campylobacter spp.
- Estafilococos coagulasa positivos
- Bacillus cereus
- Cronobacter spp.
- Vibrio spp.
- Anaerobios sulfito-reductores
- Clostridium perfringens
Podeis encontrar más información sobre esta publicación en tienda.aenor.com